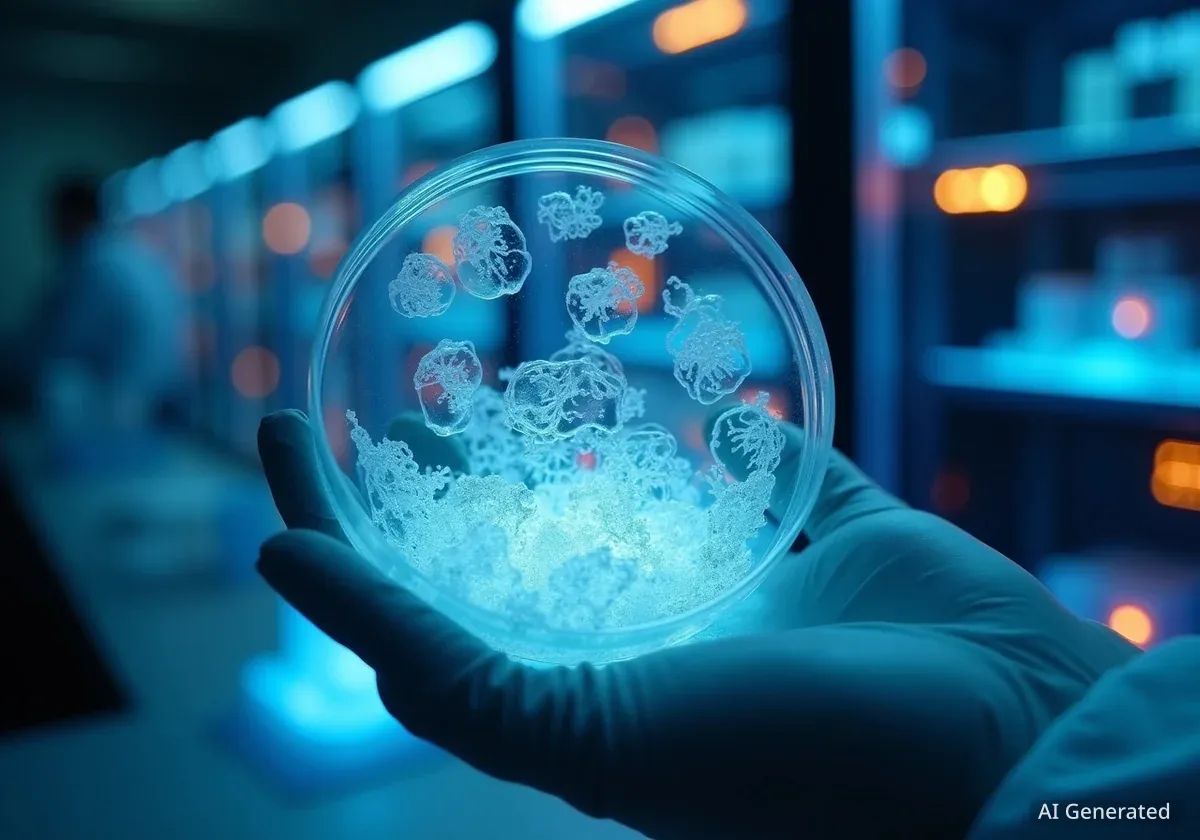

AI is Reshaping the Landscape of Mathematical Discovery
Artificial intelligence is fundamentally changing mathematical research, with new systems capable of verifying complex proofs and solving Olympiad-level problems.

Evelyn Reed is a science correspondent for Neurozzio, specializing in the intersection of artificial intelligence, computational science, and fundamental physics. She reports on breakthroughs in advanced modeling and simulation.

Artificial intelligence is fundamentally changing mathematical research, with new systems capable of verifying complex proofs and solving Olympiad-level problems.
Scientists are developing a new form of computing using lab-grown clusters of human brain cells, known as organoids, to process information with high energy efficiency.

Meta's new AI model, V-JEPA, learns intuitive physics by watching videos and shows surprise at impossible events, much like a human infant.

Following a major scientific breakthrough, private companies backed by tech giants are racing to build the first commercial nuclear fusion power plants.

Researchers have developed a new AI model, the Interpolating Neural Network, that merges physics-based simulation with machine learning for unprecedented speed.

Researchers have developed an AI framework called THOR that solves a century-old physics problem, calculating material properties over 400 times faster than previous methods.